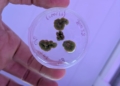

En la localidad de Mercedes, a sólo 106 kilómetros hacia el oeste de la Capital Federal, un grupo de profesionales ha fundado “un vivero dedicado a la investigación y producción de plantas de calidad, y de trazabilidad controladas en laboratorio”, según explica Alfredo Moretto, CEO de la empresa Vitrón, con sede en el kilómetro 112,5 de la Ruta 41.
Cuenta Alfredo que el origen de este vivero vanguardista se remonta al matrimonio de agrónomos mercedinos, de apellido Parra cuando, en los años ’90, la Argentina experimentaba un “boom” en el consumo de arándanos. Éstos decidieron fundar la empresa Cuinex Biotecnología SRL en la ciudad de Mercedes y a través de ella introdujeron el cultivo “in vitro” de arándanos en nuestro país, llegando a un pico de producción de 5 millones de plantas por año. Pero luego, ese “boom” fue decayendo y la familia decidió cerrar la empresa y dedicarse a seguir innovando sobre el cultivo de la vid en regiones no tradicionales. Así fue como se trasladó al sur de la provincia, donde montó un viñedo con bodega propia.

En 2010, el ingeniero agrónomo Joaquín Parra, uno de los hijos del matrimonio que había fundado Cuinex y que había trabajado codo a codo con su madre, decidió refundar el laboratorio bajo el nombre de Vitrón. Comenzó con cuestiones básicas, como vender yermas de cítricos, y enseguida se sumó su hermano, Facundo, que es enólogo. Éste posee mucha experiencia en desarrollo de plantas en vivero y asesoramiento a campos. Poco a poco fueron desarrollándose, hasta que en 2023 notaron que la empresa tenía un gran potencial, pero que para crecer, no podrían solos. Fue así que salieron a buscar ayuda en socios estratégicos, cuando dieron con Alfredo Moretto.

Moretto es martillero y corredor público, pero cuenta que jamás ejerció la profesión, ya que pertenece a una familia de larga trayectoria como emprendedores, el Grupo Moretto, oriundo de la ciudad de La Plata. Cuando se asoció en Vitrón, lo hizo en nombre de su grupo familiar, “ya que nos especializamos en potenciar empresas a través de procesos y de sistemas comprobados”, dice él mismo, y esa es su principal función como CEO de este vivero de avanzada. Pero destaca que en esa firma se reencontró con su gran pasión juvenil, ya que estudió en la escuela agropecuaria Lucio Mansilla, de General Bavio.
Así fue como se reordenó la empresa con un nuevo equipo: comenta Alfredo que sumaron a la licenciada en administración de empresas, Andrea Parra, hermana de Joaquín y de Facundo, como socia gerente y presidente de Vitrón. Además, lograron repatriar al científico argentino, radicado en Canadá, Patricio Esteves, especializado en genómica molecular y biología de precisión. “Lo convencimos de que dejara de ser empleado en el ‘Primer Mundo’, para venir a ser socio y director de las investigaciones, aportando hoy un gran prestigio a la empresa”, señala Alfredo, con una sonrisa.

El CEO aclara: “Nuestro vivero no es tradicional, porque iniciamos el proceso de producción y multiplicación de las plantas, no a través de semillas o esquejes, sino a través del cultivo de ‘meristemas’. Pero en realidad, este método ya es tradicional en los países más avanzados, porque es el único capaz de eliminar sus infecciones internas, como virus, bacterias y hongos endógenos, mejorando su funcionamiento fisiológico”.
Alfredo explica que el “meristema” es un conjunto de células que se halla dentro de los callos de las plantas, y es su parte más virgen. Detalla que su empresa trabaja principalmente el ‘meristema apical’, porque hay otros, como el radicular, etcétera.
“Así logramos aumentar su rendimiento, mejorando la calidad en cosecha e incrementando la rentabilidad neta, porque saneamos la planta madre desde su origen, bajo el control de luz, temperatura y demás factores. Aplicamos tecnologías avanzadas como la micropropagación, la embriogénesis y la organogénesis para optimizar los cultivos”, indica Moretto.
Para decirlo en palabras simples, Alfredo ejemplifica: “Una bodega tradicional de Mendoza o Salta puede traernos una vid de más de 50 años con ciertos patógenos, y a partir de sus meristemas logramos regenerar una planta completamente nueva, libre de enfermedades y rejuvenecida. Es como si tomáramos un meristema de Messi, lo clonáramos y entregáramos un Lionel sano y de 20 años”, bromea entre risas.
El CEO explica que en Europa este tipo de técnicas se desarrollan desde la década de 1990, pero en Argentina, donde predomina la agricultura extensiva, históricamente no se les dio la relevancia que merecen. “En el país debe haber apenas tres o cuatro laboratorios privados y trabajando en este campo, mientras que en Chile hay alrededor de 30, en parte porque su superficie agrícola es mucho menor que la nuestra”, agrega.
Moretto ahonda más en explicar lo específico de la empresa: “Luego la planta se coloca en algo similar a un frasco de mermelada, con una especie de gelatina en su base y luego se le aplican los nutrientes y sales específicas, que son su ‘medio de cultivo’. El desafío está en conseguir que el mismo sea efectivo, y una vez logrado, ese es nuestro protocolo, nuestra fórmula secreta, que guardamos bajo siete llaves y es la valiosa tarea que desarrollamos en la empresa, ya que lo que se investiga se produce, y lo que se produce vuelve a investigarse para mejorarlo”.

“Actualmente ya hemos desarrollado más de 40 protocolos, entre lo que se encuentra: pistacho, almendro, batata, cannabis, vid, manzana, pera, kiwi rojo, amarillo y verde, cerezas y varios más. Esto es lo más difícil de un laboratorio y donde se juega su rentabilidad”, asegura.
Sostiene Alfredo: “El productor de nuestro país es muy tradicionalista y muchas veces sospecha que nuestros productos sean ‘transgénicos’, cuando en realidad aplicamos tecnología al campo, aportando a la seguridad alimentaria y cuidando el medio ambiente. Ya que no sólo aumentamos su rendimiento, sino que al producirle y multiplicarle plantas homogéneas, saneadas y rejuvenecidas de alta calidad, necesitará usar muchos menos agroquímicos, además de mejorarle la rentabilidad”.
Actualmente Vitrón tiene una capacidad de producción de 5 millones de plantas anuales y celebra sus grandes logros en investigación, porque es la primera en desarrollar una planta “Doble Haploide” en soja a nivel mundial.
Explica Moretto que el desarrollo de una nueva variedad por métodos convencionales se logra una nueva línea genética para evaluación agronómica después de 6 a 8 generaciones de cultivo. En cambio, con una planta de “Haploide duplicado” es posible evaluarla en apenas una sola generación. Además, junto a un vivero canadiense se hallan desarrollando variaciones en plantas ornamentales a través de “mutagénesis in vitro”. Las mutaciones se dan en forma espontánea en la naturaleza, pero a través de la irradiación de rayos gamma se aumenta la frecuencia y se obtienen nuevos tipos en colores y tamaños, de especies apreciadas mundialmente, clonadas en cientos o miles de ejemplares.
Como caso de éxito, está el de la batata: gracias al saneamiento que ellos realizan en el laboratorio, la planta desarrolla mayor rendimiento en raíces, alcanzando 19,74 toneladas por hectárea, cuando el productor alcanza sólo 16,08 tns/ha, en variedades seleccionadas, y 10,34 tns/ha sin selección. En Entre Ríos, Vitrón ya impulsa la producción de cultivos no tradicionales y sustentables, como frutilla, kiwi amarillo y rojo, batata, cannabis medicinal, kiri y vetiver.

En particular, el vetiver se usa para tratamiento de efluentes y/o suelos, absorbiendo los contaminantes. En Cannabis, están investigando una planta súper hembra (tetraploide) que no se poliniza, es decir que evita la contaminación de las flores con pole que esté en el ambiente, permitiendo el cultivo de cannabis medicinal y cáñamo en una misma zona, sin que uno esté afectando la producción del otro.
Concluye el empresario: “Debemos tomar conciencia de la proyección que tiene la biotecnología vegetal en el desarrollo económico de los países. Chile, por ejemplo, generó el año pasado más ingresos por exportación de cerezas que por minería; y Perú, a través del uso de estas mismas tecnologías, pasó a ser líder mundial en producción de paltas. Argentina tiene la oportunidad de dar ese salto cultural, dejando atrás las tecnologías tradicionales e incorporando las nuevas técnicas de biotecnología. Desde Vitrón optimizamos la agricultura extensiva y la intensiva. Además, ya estamos avanzando en alianzas con empresas de toda América Latina para conformar un polo regional de producción de cultivos de alta calidad”.